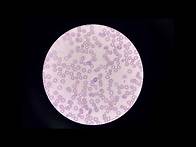

Melanonychia: When to Seek Treatment and Understanding the Signs | Dr. Mamina
Let's talk about the crucial topic of melanonychia—a condition that affects the nail, and I'll explain when it's essential to seek treatment and what signs to look for. Join me as we uncover the facts about melanonychia and its potential implications. Melanonychia, the darkening or pigmentation of the nail, can have various underlying causes ...
YouTube
· Aug 9, 2023

























![Video thumbnail for Antibiotic Classes: Mnemonic, Coverage, Mechanism of Action [Pharmacology Made Easy]](https://images.mavii.com/th/id/OVP.FkD4HR4ylzXgPqKdrGDbngHgFo?pid=Api&w=196&p=0)